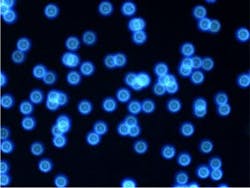
Figure4. Star image after active alignment Figure4. Star image after active alignment

Advancing Optical Lens Manufacturing
In the realm of microscopy systems for medical devices, scientific research, and industrial applications, the significance of high-resolution and long working distance objective lenses cannot be overstated. Shanghai Optics stands at the forefront of producing top-tier microscope objective lenses, including high NA, long working distance, large FOV, and APO objective lenses. This article delves into the meticulous process employed by Shanghai Optics to manufacture advanced objective lenses, focusing particularly on their utilization of active alignment technology to enhance imaging performance and minimize optical aberrations.
Manufacturing Process
Shanghai Optics employs active alignment technology at the final assembling stage to meet stringent high-resolution requirements. This method necessitates a specialized device with high imaging resolution, enabling precise alignment of lens components to optimize performance.
-
Active Alignment Setup: A sophisticated setup, as depicted in Figure 1, is utilized for active alignment. It involves the assembly of an infinite corrected objective lens with three screwed holes, mounted in a microscopy imaging system for testing. A star target with pinholes ranging from 1 to 3 microns is positioned on the stage, slightly defocused for the objective lens. A high-resolution camera captures images of the star target to evaluate alignment effectiveness.
-
Active Alignment Procedure: Before active alignment, captured star images exhibit distortions, as shown in Figure 2. However, with the implementation of active alignment, as illustrated in Figure 4, the star image displays round and concentric rings, indicating successful alignment. Figure 3 showcases the objective lens with a specialized alignment tool installed to eliminate lens aberrations and enhance performance.
-
Quality Assessment: Post-alignment, images such as those in Figure 5 and Figure 6 demonstrate the remarkable improvement in resolution, with values exceeding 1000 lp/mm. Active alignment technology serves as a cornerstone in Shanghai Optics’ manufacturing process, enhancing optical performance and yield.
Key Applications of Advanced Objective Lenses
In the domain of optical microscopy, achieving high resolution is paramount for gaining insights into microscopic structures across various scientific and industrial disciplines. This article explores the significance of specialized optical objectives, namely high-resolution, long working distance, high numerical aperture (NA), large field of view (FOV), and apochromatic (APO) lenses, and their applications in microscopy.
- High-Resolution Objectives: High-resolution objectives are indispensable tools in biology, medicine, and materials science, facilitating the observation of intricate cellular structures and aiding in medical research and technological innovation. They enable precise imaging crucial for advancing diagnostics and drug development.
- Large Field of View (FOV) Objectives: Large FOV objectives provide a broader perspective, allowing researchers to observe larger portions of specimens efficiently. They find applications in geology, materials science, and industrial microscopy, facilitating faster and more comprehensive assessments of samples and products.
- APO Objective Lenses: APO lenses ensure precise color reproduction and deliver sharper, more detailed images by correcting optical imperfections. They are vital for accurate imaging in biology, materials science, and fluorescence microscopy techniques like confocal and super-resolution microscopy, where image quality and precision are paramount.
- Long Working Distance Objectives: Long working distance objectives offer versatility in accommodating diverse samples and experimental setups. Their ample space between the lens and the specimen minimizes contamination and damage, making them invaluable in life sciences and materials science, especially for examining three-dimensional objects and surface metrology.
- High Numerical Aperture (NA) Objectives: High NA objectives gather light from wide angles, enhancing resolution and image quality. They are essential in various microscopy techniques such as fluorescence, confocal, and TIRF microscopy, enabling detailed visualization of cellular processes and nanoscale structures across scientific disciplines.
Shanghai Optics’ commitment to manufacturing excellence is evident in its utilization of cutting-edge technologies like active alignment to produce advanced objective lenses of unparalleled quality. By continually pushing the boundaries of optical engineering, Shanghai Optics plays a pivotal role in advancing scientific research, medical diagnostics, and industrial innovation.
Do not hesitate to contact Shanghai Optics today. We’d be more than happy to discuss your projects and how best they can become a success.